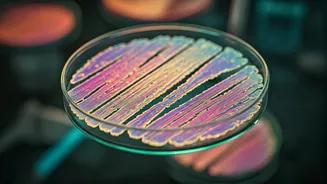
Gut Resilience: A New Perspective on Microbial Chaos

सही उत्पाद चुनें
बाजार में कई तरह के टिंटेड मॉइस्चराइज़र उपलब्ध हैं, और अपनी त्वचा के लिए सही उत्पाद चुनना महत्वपूर्ण है। सबसे पहले, अपनी त्वचा के प्रकार को पहचानें। यदि
आपकी त्वचा तैलीय है, तो ऑयल-फ्री या मैट-फ़िनिश वाले मॉइस्चराइज़र का चयन करें। सूखी त्वचा के लिए, हाइड्रेटिंग फ़ॉर्मूला बेहतर होते हैं। त्वचा के रंग को ध्यान में रखते हुए, एक ऐसा रंग चुनें जो आपकी त्वचा के रंग से मेल खाता हो। आप अपनी त्वचा के लिए सही रंग ढूंढने के लिए विभिन्न शेड्स को आजमा सकते हैं। एसपीएफ़ युक्त टिंटेड मॉइस्चराइज़र धूप से सुरक्षा प्रदान करते हैं, इसलिए इन्हें चुनना एक अच्छा विचार है। अंत में, उत्पाद की समीक्षाएँ पढ़ें और उन ब्रांडों पर ध्यान दें जिन पर आपको भरोसा है।
प्रमुख सामग्री जानें
टिंटेड मॉइस्चराइज़र में त्वचा के लिए फायदेमंद कई सामग्री होती हैं। इनमें हाइड्रेटिंग एजेंट, जैसे हाइलूरोनिक एसिड और ग्लिसरीन शामिल हैं, जो त्वचा को नमी प्रदान करते हैं। एंटीऑक्सीडेंट, जैसे विटामिन सी और ई, त्वचा को पर्यावरणीय क्षति से बचाते हैं। एसपीएफ़, जो सूर्य की हानिकारक किरणों से सुरक्षा प्रदान करता है, एक आवश्यक घटक है। कुछ टिंटेड मॉइस्चराइज़र में त्वचा को चमकदार बनाने वाले घटक भी होते हैं, जैसे कि सूक्ष्म कण। सामग्री सूची को ध्यान से देखकर, आप ऐसे उत्पाद चुन सकते हैं जो आपकी त्वचा की ज़रूरतों को पूरा करते हैं।
सही तरीके से उपयोग
टिंटेड मॉइस्चराइज़र का उपयोग करना आसान है, लेकिन सही तरीके से उपयोग करना महत्वपूर्ण है। सबसे पहले, अपने चेहरे को साफ करें और मॉइस्चराइज़र लगाएं। इसके बाद, टिंटेड मॉइस्चराइज़र की एक पतली परत लगाएं। आप अपनी उंगलियों, एक स्पंज या ब्रश का उपयोग कर सकते हैं। अधिक कवरेज के लिए, आप दूसरी परत लगा सकते हैं। टिंटेड मॉइस्चराइज़र को अच्छी तरह से ब्लेंड करना सुनिश्चित करें ताकि कोई सख्त रेखा न दिखे। यदि आप अधिक कवरेज चाहते हैं, तो आप टिंटेड मॉइस्चराइज़र के ऊपर कंसीलर और फाउंडेशन लगा सकते हैं। पूरे दिन, अपनी त्वचा को हाइड्रेटेड रखने के लिए, आप मिस्ट का उपयोग कर सकते हैं।
उत्पाद विकल्पों का अन्वेषण
बाजार में विभिन्न प्रकार के टिंटेड मॉइस्चराइज़र उपलब्ध हैं, जो विभिन्न आवश्यकताओं को पूरा करते हैं। कुछ में प्राकृतिक और हल्का कवरेज होता है, जो दैनिक उपयोग के लिए आदर्श हैं। अन्य अधिक कवरेज प्रदान करते हैं, जो त्वचा को अधिक समान बनाते हैं। एसपीएफ़ युक्त टिंटेड मॉइस्चराइज़र सूर्य से सुरक्षा प्रदान करते हैं। हाइड्रेटिंग फ़ॉर्मूला शुष्क त्वचा के लिए बेहतरीन हैं, जबकि ऑयल-फ्री फ़ॉर्मूला तैलीय त्वचा के लिए उपयुक्त हैं। प्रत्येक उत्पाद की अपनी अनूठी विशेषताएं होती हैं, इसलिए अपनी त्वचा के प्रकार और ज़रूरतों के अनुसार सही उत्पाद का चयन करना महत्वपूर्ण है।